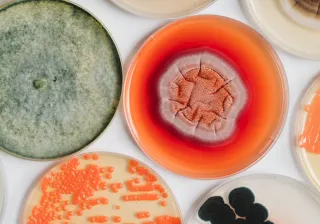
Mikrobit

VTT teamed up with ANDRITZ, Metsä Fibre and Dow to transform lignin – a pulp production side stream – into a renewable replacement for fossil-based dispersants. As a result, a new demo plant has now started up in Äänekoski, Finland.
Key facts
Opportunity: Lignin is a main side stream of pulp production that can be used as a renewable alternative to fossil-based raw materials.
Solution: Based on VTT’s innovation for producing oxidised lignin, ANDRITZ, Metsä Fibre and Dow cooperated with VTT to develop the LigniOx technology for sustainable lignin dispersants.
Result: Metsä Group's demo plant for lignin refining in connection with its Äänekoski bioproduct mill has now started.
VTT coordinated an EU-funded project called EU-LigniOx during 2017–2022 that brought together several partners, including ANDRITZ, Metsä Fibre and Dow to demonstrate the viability of oxidised lignin as a replacement for fossil-based plasticisers in concrete production. The basis for the research was provided by the doctoral thesis of VTT’s Principal Scientist Anna Kalliola, in which she examined the use of molecular oxygen to valorise technical lignins for material applications.
ANDRITZ Pulp & Paper provides sustainable technology, automation, and service solutions for the production of all types of pulp and paper. The technologies and services focus on increased production efficiency, lower overall operating costs as well as innovative decarbonisation strategies and autonomous plant operation. Metsä Fibre, as a part of Metsä Group, is a leading producer of high quality northern wood based bioproducts such as pulp, sawn timber, biochemicals, and bioenergy. Leading material science company Dow serves customers in markets such as infrastructure, packaging, mobility and consumer applications.
Commitment throughout the value chain
This year, the level of atmospheric carbon is higher than ever before, causing the global temperature to rise in parallel. New alternatives with low global warming potential help to slow down the detrimental consequences of climate change.
Lignin is a side stream of pulp production separated from the wood fibres into black liquor and currently mainly burned as bioenergy. However, it has potential as a versatile raw material for various chemical and material applications, and the industry is searching for ways to utilise it more efficiently in high-value products.
After the successful jointly funded EU-LigniOx project, VTT, Metsä Fibre and ANDRITZ have collaborated intensively on the process for the past two years, says VTT’s Kalliola:
“We have further studied and developed the LigniOx process – which involves oxidising the lignin and processing it with membrane technology. The tests have been carried out at our Bioruukki pilot centre in Espoo and at the separation technology unit in Jyväskylä. VTT’s lignin analytics have also had a crucial role in the development work,” Kalliola says, adding that the benefit of the technology is that it’s easy to integrate into a pulp mill process.
Elina Lohiniva, Business Development Director at ANDRITZ Pulp & Paper, considers the LigniOx case to be a great example of a successful EU project that is now advancing from pilot to demo plant stage.
“What makes this project great in my view is how it included the entire value chain – from concept to end product – and that all parties were excited about the technology and recognised its business potential from the beginning,” Lohiniva says.

Sustainable solution for concrete production
Metsä Group made an investment decision in spring 2024 to build a demo plant for lignin refining in connection with its Äänekoski bioproduct mill. The plant was built in cooperation with the equipment supplier ANDRITZ, and started up at the beginning of 2026.
“The EU-LigniOx project is an excellent example of how R&D projects can bring together companies in the value chain and initiate further collaboration in advancing – in this case – totally new technology and products. VTT has the expertise and research facilities that can support us in our lignin activities,” says Anna Suurnäkki, VP Research at Metsä Fibre.
Metsä Group and ANDRITZ will focus on developing the production process of the new lignin product and its integration into the bioproduct mill, as well as making the product properties suitable for various end uses. Based on the lignin product, Dow will develop high-performance bio-plasticisers for concrete and gypsum applications.
“VTT was an excellent research partner, bringing pragmatic and innovative solutions to advance breakthrough technology towards commercialisation. We are very pleased with the progress and relationship,” comments Anna Davis, R&D/TS&D Director, Dow Construction Chemicals R&D, on the successful cooperation.
Global commercial potential for lignin
VTT’s offering in the LigniOx project has included:
- Research and innovation behind the LigniOx process and oxidised lignin
- Testing and piloting at VTT’s facilities
- Deep know-how in lignin analytics and membrane filtration
- Support in upscaling from pilot level to demo plant scale.
VTT has patents related to the use of oxidised lignin and has patented the integration of the LigniOx process into a kraft pulp mill together with ANDRITZ and Metsä Fibre.
ANDRITZ is pleased to add LigniOx to their business portfolio and sees great potential in offering the process to biorefineries worldwide, working together with VTT in supporting the industrialisation of the process.
“By combining our experience, technology and top expertise, we’re able to develop new products for our customers and the market. We believe we’re only at the very beginning of utilising the full potential of lignin. The circular economy is gaining momentum and there’s an increasing demand for environmentally friendly products,” says VTT’s Customer Account Lead Sanna Haajanen.
“Developing a new technology requires open collaboration, technical capabilities and strong leadership. We are very pleased with the cooperation with ANDRITZ, Metsä Fibre and Dow,” concludes Atte Virtanen, Vice President of biomaterial processing and products at VTT.
VTT was an excellent research partner, bringing pragmatic and innovative solutions to advance breakthrough technology towards commercialisation.